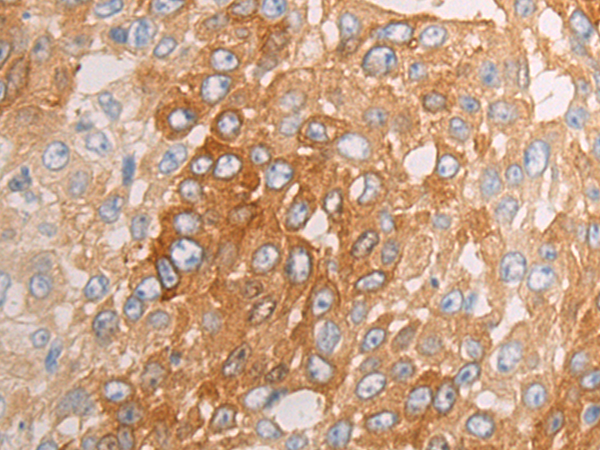

-
分类: 科研抗体货号: P12521别名: URBWD应用: WB,IHC反应种属: Human
-
分类: 科研抗体货号: P12500别名:应用: WB,IHC反应种属: Human, Mouse
-
分类: 科研抗体货号: P12520别名: ECG2; ECRG2应用: IHC反应种属: Human
-
分类: 科研抗体货号: P12498别名:应用: IHC反应种属: Human, Mouse
-
分类: 科研抗体货号: P12518别名: RBP3; E2F-1; RBAP1; RBBP3应用: WB反应种属: Human, Mouse, Rat
-
分类: 科研抗体货号: P12497别名:应用: WB,IHC反应种属: Human, Mouse, Rat
-
分类: 科研抗体货号: P12517别名: MMD1; FER1L1; LGMD2B应用: IHC反应种属: Human, Mouse
-
分类: 科研抗体货号: P12495别名: IBD10; WDR30; APG16L; ATG16A; ATG16L应用: WB,IHC反应种属: Human, Mouse
-
分类: 科研抗体货号: P12516别名:应用: IHC反应种属: Human, Mouse
-
分类: 科研抗体货号: P12493别名: FAS; OA-519; SDR27X1应用: WB,IHC反应种属: Human, Mouse, Rat

鄂公网安备42018502007531号
鄂公网安备42018502007531号

